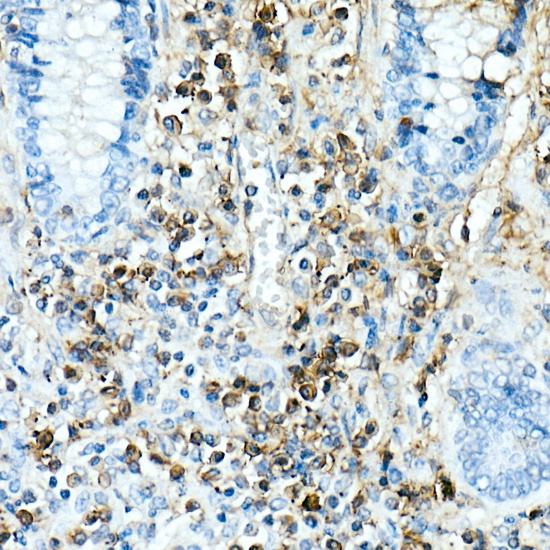
Product Image

Description
IL17A Monoclonal Antibody (CAB21266)
The IL17A Monoclonal Antibody (CAB21266) is a high-quality antibody developed for reliable detection and analysis of target proteins. This antibody, produced using monoclonal technology, specifically targets IL17A in human samples and has been validated for use in applications such as Western blot and immunohistochemistry.IL17A, also known as interleukin 17A, is a key mediator of inflammation and plays a significant role in autoimmune diseases, chronic inflammatory conditions, and host defense against pathogens.
This antibody is validated for use in IHC-P, ELISA applications and has demonstrated reactivity against Human samples.
| Product Name: | IL17A Monoclonal Antibody |
| SKU: | CAB21266 |
| Size: | 20μL, 100μL |
| Reactivity: | Human |
| Clone Number: | ARC52762 |
| Conjugate: | Unconjugated |
| Immunogen: | Recombinant protein (or fragment).This information is considered to be commercially sensitive. | ||||
| Sequence: | GITI PRNP GCPN SEDK NFPR TVMV NLNI HNRN TNTN PKRS SDYY NRST SPWN LHRN EDPE RYPS VIWE AKCR HLGC INAD GNVD YHMN SVPI QQEI LVLR REPP HCPN SFRL EKIL VSVG CTCV TPIV HHVA | ||||
| Tested Applications: | IHC-P ELISA | ||||
| Recommended Dilution: |
| ||||
| Synonyms: | IL17, CTLA8, IL-17, ILA17, CTLA-8, IL-17A, IL17A |
| Cellular Localization: | Secreted. |
| Calculated MW: | 18kDa |
This gene is a member of the IL-17 receptor family which includes five members (IL-17RA-E) and the encoded protein is a proinflammatory cytokine produced by activated T cells. IL-17A-mediated downstream pathways induce the production of inflammatory molecules, chemokines, antimicrobial peptides, and remodeling proteins. The encoded protein elicits crucial impacts on host defense, cell trafficking, immune modulation, and tissue repair, with a key role in the induction of innate immune defenses. This cytokine stimulates non-hematopoietic cells and promotes chemokine production thereby attracting myeloid cells to inflammatory sites. This cytokine also regulates the activities of NF-kappaB and mitogen-activated protein kinases and can stimulate the expression of IL6 and cyclooxygenase-2 (PTGS2/COX-2), as well as enhance the production of nitric oxide (NO). IL-17A plays a pivotal role in various infectious diseases, inflammatory and autoimmune disorders, and cancer. High levels of this cytokine are associated with several chronic inflammatory diseases including rheumatoid arthritis, psoriasis and multiple sclerosis. The lung damage induced by the severe acute respiratory syndrome coronavirus 2 (SARS-CoV-2) is to a large extent, a result of the inflammatory response promoted by cytokines such as IL17A.
| Purification Method | Affinity purification |
| Gene ID | 3605 |
| Buffer Information | Store at -20℃. Avoid freeze / thaw cycles. Buffer: PBS containing 50% glycerol and 0.05% BSA, preserved with proclin300 or sodium azide, pH 7.3. |